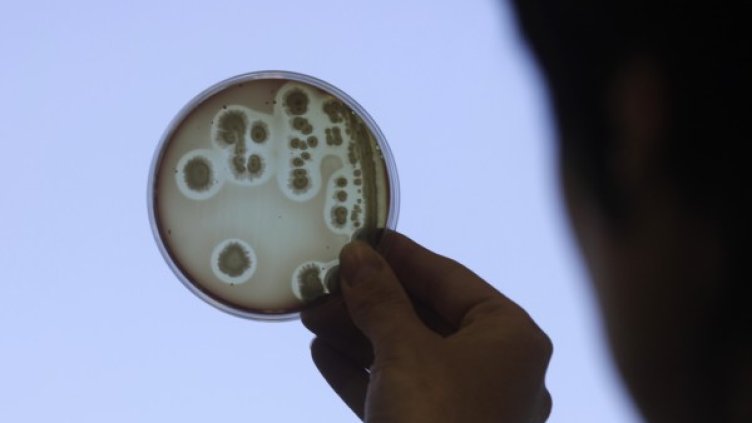
Снимка: Reuters, архив

Американски медици откриха за пръв път в САЩ "супермикроб", притежаващ устойчивост към най-силните антибиотици, предадоха световните агенции.
Бактерията е разновидност на E-coli и на нея не й въздейства силният антибиотик колистин. Микробът бил открит в организма на 49-годишна жена от щата Пенсилвания. Според медиците този случай не трябва да предизвиква паника.
При дадената пациентка болестта се поддала на лечение чрез други антибиотици, но изследователите се опасяват, че устойчивостта към антибиотика, открита в дадената бактерия, може да се разпространи на други видове бактерии, вече резистентни към други антибиотици.
Колистинът е антибиотик, представляващ последната надежда при особено опасни видове "супермикроби", като тук се включва и семейство бактерии, устойчиви към карбапенемите /клас антибиотици/.
Тези микроорганизми убиват половината от заразените пациенти и те представляват една от най-сериозните заплахи в сферата на здравеопазването.
Това се случи Dnes, за важното през деня ни последвайте и в Google News Showcase.

Политиката на Тръмп по депортация застрашава селските региони
Политиката на Тръмп по депортация застрашава селските региони  Bloomberg TV Bulgaria и Bulgaria ON AIR излъчват церемонията Real Estate Awards 2026
Bloomberg TV Bulgaria и Bulgaria ON AIR излъчват церемонията Real Estate Awards 2026  Кадър на деня за 5 юли
Кадър на деня за 5 юли  AI компаниите се борят за властта на правителствата
AI компаниите се борят за властта на правителствата  Москва дава рекордни субсидии на петролните компании, докато рафинериите им горят
Москва дава рекордни субсидии на петролните компании, докато рафинериите им горят  Китайските автомобилни марки отиват в Канада като подготовка за навлизане в САЩ
Китайските автомобилни марки отиват в Канада като подготовка за навлизане в САЩ 
 Англия изхвърли домакина Мексико от Мондиал 2026 след драматично 3:2
Англия изхвърли домакина Мексико от Мондиал 2026 след драматично 3:2  Църковен празник на 6 юли - поверия, забрани и кой празнува имен ден
Църковен празник на 6 юли - поверия, забрани и кой празнува имен ден  Седмицата започва облачно и дъждовно, но с температури до 31 градуса
Седмицата започва облачно и дъждовно, но с температури до 31 градуса  Хороскоп за 6 юли 2026 г.: Важни решения и ново начало за зодиите
Хороскоп за 6 юли 2026 г.: Важни решения и ново начало за зодиите  Бижута за милиони са откраднати от музей на Lalique във Франция
Бижута за милиони са откраднати от музей на Lalique във Франция  Джокович е на 1/4-финал на Уимбълдън след 4-сетов мач
Джокович е на 1/4-финал на Уимбълдън след 4-сетов мач 
 Холанд: Всеки иска да играе в Реал Мадрид!
Холанд: Всеки иска да играе в Реал Мадрид!  Бруно Гимараеш с исторически пропуск: Първият бразилец от 40 години, изпуснал дузпа на Световно първенство
Бруно Гимараеш с исторически пропуск: Първият бразилец от 40 години, изпуснал дузпа на Световно първенство  Анчелоти след отпадането на Бразилия: Не можехме да рискуваме с прекален натиск срещу Норвегия
Анчелоти след отпадането на Бразилия: Не можехме да рискуваме с прекален натиск срещу Норвегия  Англия изрита Мексико от Мондиал 2026 в рядко виждан трилър
Англия изрита Мексико от Мондиал 2026 в рядко виждан трилър  Столе Солбакен след историческата победа над Бразилия: Норвегия гребе заедно към мечтата
Столе Солбакен след историческата победа над Бразилия: Норвегия гребе заедно към мечтата  Спортът по телевизията днес, 6 юли
Спортът по телевизията днес, 6 юли 
 Нумерологична прогноза за 6 юли
Нумерологична прогноза за 6 юли  Сочно телешко със сладък картоф – протеинова вечеря
Сочно телешко със сладък картоф – протеинова вечеря  Мощен портал на 7/7 отключва късмета на 3 зодии
Мощен портал на 7/7 отключва късмета на 3 зодии  Йога за правилна стойка – 10-минутна практика при проблеми с кръста
Йога за правилна стойка – 10-минутна практика при проблеми с кръста  На 6 юли имен ден празнуват Валентин и Валентина
На 6 юли имен ден празнуват Валентин и Валентина  Дневен хороскоп за 6 юли, понеделник
Дневен хороскоп за 6 юли, понеделник 
 продава, Тристаен апартамент, 114 m2 София, Витоша, 439000 EUR
продава, Тристаен апартамент, 114 m2 София, Витоша, 439000 EUR  продава, Двустаен апартамент, 65 m2 София, Лозенец, 268000 EUR
продава, Двустаен апартамент, 65 m2 София, Лозенец, 268000 EUR  продава, Къща, 52 m2 Пловдив, Център, 0 EUR
продава, Къща, 52 m2 Пловдив, Център, 0 EUR  продава, Вила, 100 m2 София област, с.Шума, 39000 EUR
продава, Вила, 100 m2 София област, с.Шума, 39000 EUR  продава, Къща, 135 m2 София, Килиите в.з., 495000 EUR
продава, Къща, 135 m2 София, Килиите в.з., 495000 EUR  продава, Къща, 135 m2 София, Княжево, 495000 EUR
продава, Къща, 135 m2 София, Княжево, 495000 EUR 
 Как изглежда географията на глобалното свръхбогатство?
Как изглежда географията на глобалното свръхбогатство?  Автоинструктори: Слабата подготовка причинява повече катастрофи
Автоинструктори: Слабата подготовка причинява повече катастрофи  Проучване: Дори едно питие дневно може да повиши кръвното налягане
Проучване: Дори едно питие дневно може да повиши кръвното налягане  Българите свиват консумацията на хляб и тестени изделия, предпочитат плодове и зеленчуци
Българите свиват консумацията на хляб и тестени изделия, предпочитат плодове и зеленчуци  Марк Рюте залага на подчертани дипломатически ласкателства за запазване на американското участие в НАТО
Марк Рюте залага на подчертани дипломатически ласкателства за запазване на американското участие в НАТО  Руските жени отказват да раждат, нацията се топи с до 800 000 души на година
Руските жени отказват да раждат, нацията се топи с до 800 000 души на година 
 Книгата, която обясни Вселената: „Математически начала на натуралната философия“
Книгата, която обясни Вселената: „Математически начала на натуралната философия“  Уловиха „шепота“ на всички звездни експлозии във Вселената
Уловиха „шепота“ на всички звездни експлозии във Вселената  Еверест отстъпва: Кои са най-опасните върхове в света?
Еверест отстъпва: Кои са най-опасните върхове в света?  Преди 400 г. художник е изобразил феномен, който науката e потвърдила едва наскоро
Преди 400 г. художник е изобразил феномен, който науката e потвърдила едва наскоро  Малка бактериална тайна може да доведе до по-добри лекарства срещу рак
Малка бактериална тайна може да доведе до по-добри лекарства срещу рак  НАСА с необичайно обещание: Футболна топка ще лети до Луната, ако САЩ спечелят световното първенство
НАСА с необичайно обещание: Футболна топка ще лети до Луната, ако САЩ спечелят световното първенство 









